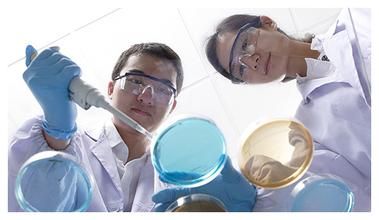

世博园汇集八大菜系33家地方品牌 本报记者 胡 钰 北京报道 近日,经各省市、港澳台世博筹备机构推荐以及上海世博会组委会联络小组、上海世博局评审,世博园已遴选出33家国内餐饮企业入驻“中华美食街”,届时,包括北京全聚德[32.29 0.06%]、天津狗不理、内蒙古小肥羊[5.13 -1.72%]、苏州得月楼、浙江五芳斋等将一齐亮相于世博园浦东园区。 据了解,这种会聚中国所有省市知名中餐品牌的集体营销并不多见,如何将多达33家的餐饮企业进行组合和整体的品牌包装,尤其是挖掘出中餐蕴含的深厚文化,是此次世博营销成功的关键所在,这也正是中餐国际化需要突破的瓶颈。 不为赚钱只赚吆喝 据记者了解,即将建成的“中华美食街”位于世博中心与主题馆之间,比邻中国馆,位置极具优势。据上海餐饮业行业协会预测,如果上海世博会期间有7500万参观人次,按每人次在园区内至少消费一顿饭的话,餐饮商机就至少有18亿元,而7500万人次走出世博园后对于中餐的口碑营销效果将远远大于这笔直接收益。 而且,在“中华美食街”的周边,还将有八大菜系、上海特色、巷里风情等,共同组合成为整个世博浦东园区的餐饮服务中心。长年从事餐饮连锁研究的北大纵横管理咨询集团高级合伙人史俊认为,这对于中餐业走向世界是一个绝好的机会。“餐饮业与制造业等领域一样,是中国提升国际地位的重要板块和手段之一,而且餐饮业更可直观感受、更易被世界所理解和接受,可以作为提升国家形象和影响力的直接切入点。” 此外,在上海世博园区餐饮服务供应商中,中餐企业也占据了不少席位。据悉,俏江南、真功夫、老娘舅等品牌都将集中展示其特色菜品,更多的中餐企业是抱着“不为赚钱、只赚吆喝”的心态来面对世博商机,重在品牌层面的打造。同时,在这些餐饮企业看来,世博会对自身标准化、安全控制等也是一次锤炼。 “中国餐饮借世博走向世界已经具备了一定的基础。”史俊认为,目前已有全聚德、俏江南、小肥羊等数家中国餐饮企业在国际化道路上做出了有益尝试,尤其是在品牌宣传方面迈出了重要的第一步。此外,北京奥运会对于包括餐饮业在内的中国形象起到了“提升”的作用,而上海世博会正是延续了这种效应,是中餐业做“深入”展示的机会。 形象整合是营销关键 据了解,世博会举办期间除了中餐企业,还有世界各地的美食餐饮进行展示,包括各国家馆也将设置自己民族餐饮的区域或现场展示。这样一来,“中华美食街”上的33家企业以及世博园内更多的中餐企业想要脱颖而出,并非易事。 按照记者目前获得的资料,包括北京全聚德、天津狗不理、内蒙古小肥羊、苏州得月楼、浙江五芳斋、福建沙县小吃、重庆陶然居、四川巴国布衣、陕西西安饭庄、香港美心酒家、澳门茶餐厅、台湾老董牛肉面等知名品牌都将汇集于“中华美食街”,门类繁多,菜品、餐饮环境特色、服务等呈多元化,而外国游客不可能在短时间内对如此庞大的中餐文化群做深入、系统了解。 “在世博园内做商业集群容易,但在世博会半年有限的时间段内、固定的区域内提升中餐的认知度,就是一个高难度课题,这对组织者提出了高要求。” 史俊表示,在通过一系列的活动和推介会来营销时,切忌靠单个店铺的体验,而是要进行有顺序、有目的的展示,将33家餐饮企业做组合、定位,进行整体的品牌包装。“有的是地方菜系,有的是传统小吃,可以把33家企业做归类、提炼式的集体展示。”史俊打了个比方,33家餐饮企业是原材料,每一份食材已相当丰富,关键是如何将其烩炒到一锅中,以明确的主题推介出去。 而在世博园以外的中餐业也将影响到园内的营销效果,尤其是散布在上海各个角落的本地餐馆,无论大小和管理水平,都在某种意义上承担了世博会编外形象大使的职责。根据记者了解,上海世博会的园区距离市区几大繁华地段并不远,而且届时上海的轨道交通等将极为便利,很多游客不会仅限于世博园的游览。上海餐饮行业协会会长何义钊表示,世博会对餐饮业的作用,甚至要考虑辐射到长江三角洲地区。而且,如此长时间、大规模的餐饮供应是上海餐饮供应历史上从未遇见过的,加之世博会举办期间正值7、8、9月的高温闷热天气,对食品的安全卫生将是极大的考验。而以上这些因素都将直接影响到中国餐饮的世界形象,是对组织者的重大考验。 改变中餐低档喧闹的印象 “紧扣‘体验文化’是世博会中国餐饮集体营销的关键所在。”史俊指出,中国餐饮的国际化路程还很漫长,除了在菜品、管理和服务上亟待提高外,如何与中国文化结合一直是其短板。“吃,说到底是体验食物背后文化的过程,外国游客在吃烤鸭的同时,应该让他们了解烤鸭背后的中国历史。”日本爱知世博会策划专家也建议,上海世博餐饮一定要体现中国文化特色。
记者了解到,尽管为中式餐饮提供营销支撑的机构和公关公司很多,也不乏很多专业手法的运用,但传递什么样的文化价值却一直难有突破。与美国餐饮的快速便捷、法国大餐的精致高雅等国外餐饮的清晰品牌定位相比,中式餐饮始终显得定位模糊,国外一些唐人街的中餐馆甚至给人留下了低档、喧闹的印象。因此,中餐应抓紧世博会契机,改变这个传统印象。 “其实,就不少中餐业的单个企业来讲,其文化内涵已经相当丰富,但缺乏的是如何将深厚内涵提炼,并浅显易懂、朗朗上口地表达出来,以便易于国外游客的认知和传播。”史俊建议,中餐文化营销应集中于三个层面:传递5000年中国文化、传递中餐从古至今对健康饮食的贡献、传递中餐的艺术。